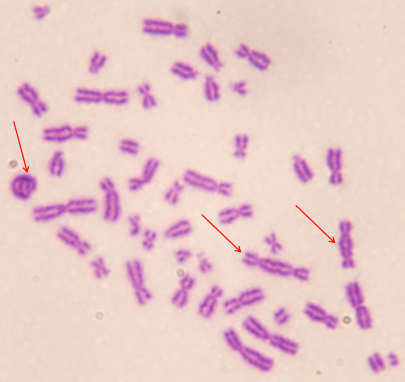
4

Munkatársak
- Dr. Lumniczky Katalin MD, PhD, osztályvezető
- Balázs Katalin, biológus, PhD hallgató
- Csordás Ilona, biotechnológus, MSc
- Galgand Kinga, biotechnológus, MSc hallgató
- Dr. Hargitai Rita, biológus, PhD
- Kis Enikő, biológus, MSc
- Dr. Persa Eszter, biológus, PhD
- Sándor Nikolett, biológus, PhD
- Szarka Eszter, PhD
- Dr. Szatmári Tünde, biológus, PhD
- Erdélyi Renáta, titkárnő – BSC, humánfejlesztő szakember
- Csabádi Mariann - kisegítő
- Haller Károly-kisegítő
Az osztály feladatai:
- Tudományos kutatási tevékenységet végez a sugárzás ártalmas hatásai elleni védekezés tudományos megalapozása céljából; kutatásaink célja az emberi sugárártalom korai felismerésére és gyógykezelésére alkalmas eljárások kidolgozása, valamint a sugárbiológiai hatások, az ionizáló sugárzás közegészségügyi, orvostudományi hasznosításának elősegítése. Konkrétan vizsgáljuk: 1) a sugárártalmak kimutatásának és módosításának módszereit; 2) az ionizáló sugárzások hatását az emberi környezet elemeire; 3) a sugárzás és egyéb fizikai, kémiai és/vagy biológiai ágensek együttes hatását az emberre és annak környezetére; 4) a sugártechnológia közegészségügyi és környezetvédelmi alkalmazhatóságait.
- Közreműködünk a sugárbiológiai hatások sugárterápiás és daganatterápiás hasznosításában;
- Közreműködünk az egyéni sugárérzékenység meghatározásában és a biodozimetriai vizsgálatokban;
- Felmérjük és értékeljük a szakterületen folyó hazai és külföldi kutatásokat és fejlesztéseket, javaslatokat dolgozunk ki azok eredményeinek adaptálására és a hazai tennivalókra vonatkozóan;
- Javaslatot teszünk a sugárbiológia, sugáregészségügy rövid és hosszú távú programjaira;
- Közreműködünk sugársérült vagy arra gyanús személyek egészségügyi ellátásában az atomenergiáról szóló 1996. évi CXVI. törvény egyes rendelkezéseinek végrehajtásáról szóló 16/2000. (VI. 8.) EüM rendeletben megfogalmazottak szerint. Túl-expozíció gyanúja esetén biodozimetriai vizsgálatot végzünk, és - az országban egyedüli laboratóriumként - megbecsüljük az elszenvedett sugárdózist, illetve annak várható következményeit;
- Közreműködünk a sugársérültek orvosi ellátására kijelölt egészségügyi intézmények szakmai felkészítésében, megszervezzük a rendszeres sugárorvostani továbbképzést, és egyéni konzultációkat tartunk a „Sugársérültek ellátása” témában a kijelölt egészségügyi intézmények munkatársai részére;
- Szakvéleményt adunk ionizáló-sugárzás okozta foglalkozási megbetegedés gyanúja esetén
- Közreműködünk sugárorvostani továbbképző és egészségügyi felvilágosító anyagok összeállításában;
- Az osztály részt vesz a sugárterápiás szakorvos képzésben;
- Közreműködik az egyetemek, a főiskolák, más intézmények által irányított képzési és továbbképzési feladatok ellátásában;
- Egyéni továbbképzési lehetőséget és szakmai irányítást biztosít főiskolai, egyetemi, illetve PhD hallgatók számára;
- Részt vesz a WHO/REMPAN munkájában;
- Részt vesz, előadásokat tart és megszervez különféle szakmai és tudományos hazai és nemzetközi rendezvényeket, konferenciákat;
- Nemzetközi és hazai tudományos folyóiratokban közzéteszi a tudományos kutatómunka eredményeit;
- Részt vesz a tudományos közélet által mindenkor meghatározott szakmai fokozatok és tevékenységek megvalósításában, és támogatja azok elérésére a munkatársaikat;
- Hazai és külföldi ösztöndíjasokat fogad.
A. Kutatási tevékenység

Az osztály fő kutatási területe az ionizáló sugárzások biológiai hatásainak tanulmányozása, e hatások molekuláris és celluláris alapjainak vizsgálata, különös tekintettel a kisdózisok (100 mGy alatti sugárzások) biológiai hatásaira. Az utóbbi évtizedekben exponenciálisan növekedett az olyan orvosi diagnosztikai vizsgálatok (CT, PET, PET-CT, nukleáris medicinában alkalmazott izotópos vizsgálatok, stb.) száma, amelyek kisdózisú sugárexpozícióval járnak. Ezen vizsgálatok során az egy vizsgálat alatt elszenvedett dózis nagyon alacsony, de a többszöri expozíció miatt a dózisok biológiai hatásai kumulálódhatnak. Jelenleg a kis dózisú ionizáló sugárzás biológiai hatásairól és azok hosszú távú egészségügyi következményeiről nagyon keveset tudunk. Nemzetközi kutatócsoportok által végzett epidemiológiai vizsgálatok kimutatták, hogy a diagnosztikában alkalmazott dózistartományok is képesek statisztikailag mérhetően megemelni a rosszindulatú daganatok előfordulásának a gyakoriságát. Vannak továbbá arra utaló vizsgálatok is, hogy a kis dózisú sugárexpozíció, hasonlóan a nagy dózisú sugárexpozícióhoz hosszú távon fokozza a kardiovaszkuláris, cerebrovaszkuláris és kognitív zavarokat különösen a sugárzásra fokozottan érzékeny populációkban. Mindezen megfigyelések fényében és tekintettel arra, hogy a kis dózisokkal exponált potenciálisan egészséges emberek száma gyorsan nő, a kis dózisú sugárexpozíció biológiai hatásainak, korai és késői következményeinek a megismerése rendkívül fontos.
Az osztály egyik fő célkitűzése a kisdózisú sugárzások rövid és hosszú távú biológiai hatásainak tanulmányozása az alábbi témákban:
- Az ionizáló sugárzásoknak a nem DNS célpontú hatásainak a vizsgálata. Ezek a hatások a genomi instabilitást, bystander (szomszédsági) hatást, szisztémás sugárválaszokat foglalják magukba és arra utalnak, hogy a sejtek közötti kommunikáció, mikro/makrokörnyezeti változások, az immunrendszer állapota legalább ugyanolyan fontos paraméterek az adott sugárválasz kialakításában, mint a közvetlen sugártalálatot szenvedett sejtek által elnyelt dózis. Kutatócsoportunk a sejtek által kibocsátott extracelluláris vezikulák (EV) szerepét tanulmányozza az ionizáló sugárzások által kiváltott bystander, abszkopális és szisztémás hatásokban, valamint az extracelluláris vezikulák szerepét a sugárzás által indukált leukémiák előidézésében. Kimutattuk in vivo egérmodellben, hogy az egésztest besugárzást elszenvedett egerekből izolált EV-k a direkt besugárzáshoz hasonló DNS-károsodásokat és elváltozásokat okoztak egerek vérképző rendszerében, valamint a citokin-termelésben. Az EV-k tartalmát vizsgálva néhány olyan mikroRNSt azonosítottunk, melyeknek szerepe lehet ezeknek a hatásoknak a kialakításában.

Cells 2022 ,11(1), 155; https://doi.org/10.3390/cells11010155
- Egy másik, ehhez a témakörhöz kapcsolódó projektben a kisdózisú sugárzások hosszú távú hatásait vizsgáljuk az agyban, egér és patkány modellekben.

Front. Immunol., 05 May 2017 | https://doi.org/10.3389/fimmu.2017.00517
- Különböző hazai és egyéb európai onkológiai klinikákkal együttműködve sugárterápiával kezelt daganatos betegek véréből vizsgáljuk a prognosztikai és prediktív szolubilis biomarkereket, amelyek jellemezhetik a betegséget illetve a kezelésre adott terápiás választ.
- Az OECD által kidolgozott AOP (adverse outcome pathway) kémiai toxicitás becslésére szolgáló módszer sugárbiológiában és a sugárvédelemben való alkalmazásának a lehetőségeit vizsgáljuk egy nemzetközi munkacsoportban.
- Legújabb kutatási témaként egy nemzetközi konzorciumon belül a Környezetegészségügyi Laboratóriumi Osztállyal kollaborálva vizsgáljuk a különböző kémiai ágensek (mycoplasmák, bisphenolok) immuntoxicitását, illetve szenzitizáló hatását a légúti allergiákra. In vivo és in vitro kísérletekkel feltérképezzük azokat a mechanizmusokat, amelyek az illető ágens szenzitizáló hatásához vezetnek
Támogatások:
Kutatási tevékenységünket hazai és nemzetközi támogatással végezzük. Legutóbbi kutatási pályázatok:
K-124879 Prosztata tumoros betegek túlélésének és a sugárterápia következtében kialakuló késői mellékhatások kockázatának a becslésére alkalmas citogenetikai és immunológiai markereknek az azonosítása
Projektgazda: NKFI-6
Időtartam: 2017-09-01 - 2021-08-31
662287 (CONCERT) European Joint Programme for the Integration of Radiation Protection Research — CONCERT + LEU-TRACK
Projektgazda: Euratom Research and Training Programme 2014-2018
Időtartam: 2015-06-01 - 2020-05-31
101057014 PARC (Partnership for the Assessment of Risks from Chemicals)
projektgazda: HORIZON-HLTH-2021-ENVHLTH-03 -HORIZON-COFUND
Időtartam: 84hónap
B: Biodozimetria
Összhangban az atomenergiáról szóló 1996. évi CXVI. törvény egyes rendelkezéseinek végrehajtásáról szóló 16/2000. (VI. 8.) EüM rendeletben megfogalmazottakkal az osztály az országban egyedüli laboratóriumként túl-expozíció gyanúja esetén biodozimetriai vizsgálatot végez, és megbecsüli az elszenvedett sugárdózist, illetve annak várható következményeit. Két vizsgálatot végzünk rutinszerűen: a dicentrikus kromoszóma tesztet és a mikronukleusz tesztet. Sugárspecifikus gének génexpressziós vizsgálata illetve γH2AX teszt szintén a vizsgálati paneleink közé tartozik.
A dicentrikus kromoszóma assay a biodozimetriai vizsgálatok gold standard-je a Nemzetközi Atomenergia Ügynökség ajánlása szerint. Perifériás limfociták metafázisos kromoszómáit vizsgálva a sugárhatásra specifikusan a két centroméra-befűződést tartalmazó kromoszómák ezrelékes arányából következtetünk a sugárdózisra.

A mikronukleusz assay során a sejtosztódás végén kialakuló két sejtmagon kívül a perifériás limfociták citoplazmájában megjelenő, károsodott DNS tartalommal rendelkező apró sejtmag-szerű képződmények ezrelékes arányából szintén meg lehet becsülni az elnyelt dózist. A mikronukleuszok keletkezése nem sugárspecifikus jelenség, egyéb genotoxikus ágensekre és különféle betegségek során is megjelennek.
A génexpressziós vizsgálatokat kvantitatív PCR készülékkel végezzük, sugárspecifikus gének expresszióját vizsgálva.

A H2Ax hiszton a DNS szál kettős töréseinek következtében foszforilálódik – ezen formája fluoreszcens festékkel jelölt antitesttel kimutathatóvá válik. A jelölt γH2Ax fókuszok száma arányos az elnyelt dózissal.
Módszertani összemérések
- Rendszeresen részt veszünk nemzetközi biodozimetriai hálózatok munkájában és ezen belül éves gyakoriságú nemzetközi összemérésekben. (RENEB: Running the European Network of Biological and retrospect- https://www.reneb.net/)
- 2021-ben a Bundeswehr Institute of Radiobiology (BSF), Munich, Germany munkatársai szervezésében 27 ország 46 intézményében 86 biodozimetriai csoport munkájának összemérése zajlott le. Nyolc biodozimetriai módszer (dicentrikus kromoszóma assay, mikronukleusz assay, génexpressziós vizsgálatok és γH2Ax hiszton foszforiláció vizsgálata, állandó transzlokációs assay, korai kromoszóma kondenzációk vizsgálata, elektron paramágneses rezonancia és optikailag stimulált vagy termolumineszcencia vizsgálatok) segítségével került sor erre az összemérésre, amelyek közül csoportunk tagjai négy módszerrel (dicentrikus kromoszóma assay, mikronukleusz assay, génexpressziós vizsgálatok és γH2Ax hiszton foszforiláció vizsgálata) vettek részt.
- 2019-ben a RENEB/EURADOS összevont nemzetközi összemérés megszervezésére négy különböző intézmény (LUND/Svédország, BSF/Németország, IRSN/Franciaország és PHE/Nagy Britannia) munkatársai szervezésében került sor. Ennek során Biodozimetria csoportunk tagjai három módszer (dicentrikus kromoszóma assay, mikronukleusz assay valamint a génexpressziós vizsgálatok) összemérésében vettek részt.
- 2017-ben a franciaországi Sugárvédelmi és Nukleáris Biztonsági Intézet (Institut de Radioprotection et de Sûreté Nucléaire (IRSN), Paris, France) munkatársai szervezésében a mikronukleusz assay módszertani összemérésében vettünk részt.
- 015-ben a Stockholmi egyetem (Stockholm University, Centre for Radiation Protection Research, Department of Molecular Biosciences, The Wenner-Gren Institute, Stockholm, Sweden) munkatársainak a szervezésében egy sugárzással kapcsolatos tömegszerencsétlenség esetére való felkészülés/tréning gyakorlaton vettünk részt, ahol alkalmunk adódott begyakorolni mind a koordináló labor, mind a segítségnyújtó labor feladatait.
- Az elmúlt három évben (2019-2021) a mikronukleusz esszé akridine-orange-os festékkel való kiértékelését is alkalmazzuk és ezzel a módszerrel minden évben rész veszünk a Gent-i egyetem Orvosi és Egészségügyi karának (Faculty of Medicine and Health Sciences, Ghent University, Gent, Belgium) éves akkreditációs eljárásához szükséges nemzetközi összemérésben.
- Belföldi felkérésre automata mikronukleusz számláló rendszer beállításában és validálásában vettünk a Budapesti Műszaki Egyetemmel kollaborációban.
Sugárexpozíció és genotoxikus kockázat becslése exponált-gyanús személyekben
- Többlet sugárexpozíciónak potenciálisan kitett munkavállalók vérmintáinak vizsgálata
- Kórházi dolgozók citosztatikumok okozta genotoxikus kockázatának a becslése
Nemzetközi és hazai összemérésekből született kollaborációs közlemények listája:
- M Abend,S A Amundson, C Badie, K Brzoska , R Hargitai,R Kriehuber, S Schüle , E Kis , S A Ghandhi, K Lumniczky, S R Morton , G O'Brien , D Oskamp, P Ostheim, C Siebenwirth, I Shuryak , T Szatmári, M Unverricht-Yeboah, E Ainsbury, C Bassinet, U Kulka, U Oestreicher, Y Ristic, F Trompier, A Wojcik, L Waldner, M Port.. Inter-laboratory comparison of gene expression biodosimetry for protracted radiation exposures as part of the RENEB and EURADOS WG10 2019 exercise Sci Rep. 2021 May 7;11(1):9756. doi: 10.1038/s41598-021-88403-4.
- Gregoire E, Barquinero JF, Gruel G, Benadjaoud M, Martinez JS, Beinke C, Balajee A, Beukes P, Blakely WF, Dominguez I, Pham ND, Monteiro Gil O, Güçlü I, Guogyte K, Hadjidekova SP, Hadjidekova V, Hande P, Jang S, Lumniczky K, Meschini R, Milic M, Montoro A, Moquet J, Moreno M, Norton FN, Oestreicher U, Pajic J, Sabatier L, Sommer S, Testa A, Terzoudi G, Valente M, Venkatachalam P, Vral A, Wilkins RC, Wojcik A, Zafiropoulos D, Kulka U. RENEB Inter-Laboratory Comparison 2017: limits and pitfalls of ILCs. Int J Radiat Biol. 2021 May 10:1-52. doi: 10.1080/09553002.2021.
- Endesfelder D, Oestreicher U, Kulka U, Ainsbury EA, Moquet J, Barnard S, Gregoire E, Martinez JS, Trompier F, Ristic Y, Woda C, Waldner L, Beinke C, Vral A, Barquinero JF, Hernandez A, Sommer S, Lumniczky K, Hargitai R, Montoro A, Milic M, Monteiro Gil O, Valente M, Bobyk L, Sevriukova O, Sabatier L, Prieto MJ, Moreno Domene M, Testa A, Patrono C, Terzoudi G, Triantopoulou S, Histova R, Wojcik A. RENEB/EURADOS field exercise 2019: robust dose estimation under outdoor conditions based on the dicentric chromosome assay. Int J Radiat Biol. 2021;97(9):1181-1198. doi: 10.1080/09553002.2021.1941380.
- Tímea Hülber, Zsuzsa S. Kocsis, Enikő Kis, Géza Sáfrány & Csilla Pesznyák (2020) A scanning and image processing system with integrated design for automated micronucleus scoring, International Journal of Radiation Biology, DOI: 10.1080/09553002.2020.1722863
- Hülber, Tímea ; Kis, Enikő ; Zsuzsa Kocsis, S. ; Sáfrány, Géza ; Pesznyák, Csilla [P286] Study on semi-automatically evaluated micronucleus frequency changes in patients with prostate adenocarcinoma undergoing low and high dose rate brachytherapy PHYSICA MEDICA-EUROPEAN JOURNAL OF MEDICAL PHYSICS 52 : Suppl. 1 p. 182 , 1 p. (2018)
- Kis Enikő: Magyar részvétel az európai biodozimetriai hálózat (RENEB) kialakításában HADMÉRNÖK, XIII: 3, pp. 119-135 (2018)
- Kulka U, Abend M, Ainsbury E, Badie C, Barquinero JF, Barrios L, Beinke C, Bortolin E, Cucu A, De Amicis A, Domínguez I, Fattibene P, Frøvig AM, Gregoire E, Guogyte K, Hadjidekova V, Jaworska A, Kriehuber R, Lindholm C, Lloyd D, Lumniczky K, Lyng F, Meschini R, Mörtl S, Della Monaca S, Monteiro Gil O, Montoro A, Moquet J, Moreno M, Oestreicher U, Palitti F, Pantelias G, Patrono C, Piqueret-Stephan L, Port M, Prieto MJ, Quintens R, Ricoul M, Romm H, Roy L, Sáfrány G, Sabatier L, Sebastià N, Sommer S, Terzoudi G, Testa A, Thierens H, Turai I, Trompier F, Valente M, Vaz P, Voisin P, Vral A, Woda C, Zafiropoulos D, Wojcik A. RENEB - Running the European Network of biological dosimetry and physical retrospective dosimetry. International Journal of Radiation Biology. 2017 93:2-14.
- Ainsbury E, Badie C, Barnard S, Manning G, Moquet J, Abend M, Antunes AC, Barrios L, Bassinet C, Beinke C, Bortolin E, Bossin L, Bricknell C, Brzoska K, Buraczewska I, Castaño CH, Čemusová Z, Christiansson M, Cordero SM, Cosler G, Monaca SD, Desangles F, Discher M, Dominguez I, Doucha-Senf S, Eakins J, Fattibene P, Filippi S, Frenzel M, Georgieva D, Gregoire E, Guogyte K, Hadjidekova V, Hadjiiska L, Hristova R, Karakosta M, Kis E, Kriehuber R, Lee J, Lloyd D, Lumniczky K, Lyng F, Macaeva E, Majewski M, Vanda Martins S, McKeever SW, Meade A, Medipally D, Meschini R, M'kacher R, Gil OM, Montero A, Moreno M, Noditi M, Oestreicher U, Oskamp D, Palitti F, Palma V, Pantelias G, Pateux J, Patrono C, Pepe G, Port M, Prieto MJ, Quattrini MC, Quintens R, Ricoul M, Roy L, Sabatier L, Sebastià N, Sholom S, Sommer S, Staynova A, Strunz S, Terzoudi G, Testa A, Trompier F, Valente M, Hoey OV, Veronese I, Wojcik A, Woda C. Integration of new biological and physical retrospective dosimetry methods into EU emergency response plans - joint RENEB and EURADOS inter-laboratory comparisons. International Journal of Radiation Biology. 2017 Jan;93(1):99-109.
- Oestreicher U, Samaga D, Ainsbury E, Antunes AC, Baeyens A, Barrios L, Beinke C, Beukes P, Blakely WF, Cucu A, De Amicis A, Depuydt J, De Sanctis S, Di Giorgio M, Dobos K, Dominguez I, Duy PN, Espinoza ME, Flegal FN, Figel M, Garcia O, Monteiro Gil O, Gregoire E, Guerrero-Carbajal C, Güçlü İ, Hadjidekova V, Hande P, Kulka U, Lemon J, Lindholm C, Lista F, Lumniczky K, Martinez-Lopez W, Maznyk N, Meschini R, M'kacher R, Montoro A, Moquet J, Moreno M, Noditi M, Pajic J, Radl A, Ricoul M, Romm H, Roy L, Sabatier L, Sebastià N, Slabbert J, Sommer S, Stuck Oliveira M, Subramanian U, Suto Y, Que T, Testa A, Terzoudi G, Vral A, Wilkins R, Yanti L, Zafiropoulos D, Wojcik A. RENEB intercomparisons applying the conventional Dicentric Chromosome Assay (DCA). International Journal of Radiation Biology. 2017 93:20-29.
- Elizabeth Ainsbury, Christophe Badie, Stephen Barnard, Grainne Manning, Jayne Moquet, Michael Abend, Ana Catarina Antunes, Lleonard Barrios, Celine Bassinet, Christina Beinke, Emanuela Bortolin, Lily Bossin, Clare Bricknell, Kamil Brzoska, Iwona Buraczewska, Carlos Huertas Castaño, Zina Čemusová, Maria Christiansson, Santiago Mateos Cordero, Guillaume Cosler, Sara Della Monaca, François Desangles, Michael Discher, Inmaculada Dominguez, Sven Doucha-Senf, Jon Eakins, Paola Fattibene, Silvia Filippi, Monika Frenzel, Dimka Georgieva, Eric Gregoire, Kamile Guogyte, Valeria Hadjidekova, Ljubomira Hadjiiska, Rositsa Hristova, Maria Karakosta, Enikő Kis, Ralf Kriehuber, Jungil Lee, David Lloyd, Katalin Lumniczky, Fiona Lyng, Ellina Macaeva, Matthaeus Majewski, S. Vanda Martins, Stephen W.S. McKeever, Aidan Meade, Dinesh Medipally, Roberta Meschini, Radhia M’kacher, Octávia Monteiro Gil, Alegria Montero, Mercedes Moreno, Mihaela Noditi, Ursula Oestreicher, Dominik Oskamp, Fabrizio Palitti, Valentina Palma, Gabriel Pantelias, Jerome Pateux, Clarice Patrono, Gaetano Pepe, Matthias Port, María Jesús Prieto, Maria Cristina Quattrini, Roel Quintens, Michelle Ricoul, Laurence Roy, Laure Sabatier, Natividad Sebastià, Sergey Sholom, Sylwester Sommer, Albena Staynova, Sonja Strunz, Georgia Terzoudi, Antonella Testa, Francois Trompier, Marco Valente, Olivier Van Hoey, Ivan Veronese, Andrzej Wojcik & Clemens Woda (2017) Integration of new biological and physical retrospective dosimetry methods into EU emergency response plans – joint RENEB and EURADOS inter-laboratory comparisons, International Journal of Radiation Biology, 93:1, 99-109, DOI: 10.1080/09553002.2016.1206233
- Julie Depuydt, Ans Baeyens, Stephen Barnard, Christina Beinke, Anett Benedek, Philip Beukes, Iwona Buraczewska, Firouz Darroudi, Stefania De Sanctis, Inmaculada Dominguez, Octávia Monteiro Gil, Valeria Hadjidekova, Enikő Kis, Ulrike Kulka, Florigio Lista, Katalin Lumniczky, Radhia M’kacher, Jayne Moquet, Doina Obreja, Ursula Oestreicher, Jelena Pajic, Nuria Pastor, Ljubomira Popova, Elisa Regalbuto, Michelle Ricoul, Laure Sabatier, Jacobus Slabbert, Sylwester Sommer, Antonella Testa, Hubert Thierens, Andrzej Wojcik & Anne Vral (2017) RENEB intercomparison exercises analyzing micronuclei (Cytokinesis-block Micronucleus Assay), International Journal of Radiation Biology, 93:1, 36-47, DOI: 10.1080/09553002.2016.1206231
- Beata Brzozowska, Elizabeth Ainsbury, Annelot Baert, Lindsay Beaton-Green, Leonardo Barrios, Joan Francesc Barquinero, Celine Bassinet, Christina Beinke, Anett Benedek, Philip Beukes, Emanuela Bortolin, Iwona Buraczewska, Christopher Burbidge, Andrea De Amicis, Cinzia De Angelis, Sara Della Monaca, Julie Depuydt, Stefania De Sanctis, Katalin Dobos, Mercedes Moreno Domene, Inmaculada Domínguez, Eva Facco, Paola Fattibene, Monika Frenzel, Octávia Monteiro Gil, Géraldine Gonon, Eric Gregoire, Gaëtan Gruel, Valeria Hadjidekova, Vasiliki I. Hatzi, Rositsa Hristova, Alicja Jaworska, Enikő Kis, Maria Kowalska, Ulrike Kulka, Florigio Lista, Katalin Lumniczky, Wilner Martínez-López, Roberta Meschini, Simone Moertl, Jayne Moquet, Mihaela Noditi, Ursula Oestreicher, Manuel Luis Orta Vázquez, Valentina Palma, Gabriel Pantelias, Alegria Montoro Pastor, Clarice Patrono, Laure Piqueret-Stephan, Maria Cristina Quattrini, Elisa Regalbuto, Michelle Ricoul, Sandrine Roch-Lefevre, Laurence Roy, Laure Sabatier, Lucia Sarchiapone, Natividad Sebastià, Sylwester Sommer, Mingzhu Sun, Yumiko Suto, Georgia Terzoudi, Francois Trompier, Anne Vral, Ruth Wilkins, Demetre Zafiropoulos, Albrecht Wieser, Clemens Woda & Andrzej Wojcik (2017) RENEB accident simulation exercise, International Journal of Radiation Biology, 93:1, 75-80, DOI: 10.1080/09553002.2016.1206230
- Kulka U, Ainsbury L, Atkinson M, Barnard S, Smith R, Barquinero JF, Barrios L, Bassinet C, Beinke C, Cucu A, Darroudi F, Fattibene P, Bortolin E, Monaca SD, Gil O, Gregoire E, Hadjidekova V, Haghdoost S, Hatzi V, Hempel W, Herranz R, Jaworska A, Lindholm C, Lumniczky K, M'kacher R, Mörtl S, Montoro A, Moquet J, Moreno M, Noditi M, Ogbazghi A, Oestreicher U, Palitti F, Pantelias G, Popescu I, Prieto MJ, Roch-Lefevre S, Roessler U, Romm H, Rothkamm K, Sabatier L, Sebastià N, Sommer S, Terzoudi G, Testa A, Thierens H, Trompier F, Turai I, Vandevoorde C, Vaz P, Voisin P, Vral A, Ugletveit F, Wieser A, Woda C, Wojcik A. Realising the European Network of Biodosimetry: RENEB-status quo. Radiat Prot Dosimetry. 2014 Sep 9. pii: ncu266.
C. Oktatás
A 487/2015. (XII.30.) Kormányrendeletben előírtak szerint a sugárveszélyes munkahelyen dolgozóknak rendszere sugárvédelmi képzésen és továbbképzésen kell részt venniük. A képzések szakmai tartalma az Országos Atomenergiai Hivatal (OAH) hivatalos tematikája alapján kerül kidolgozásra és a tanfolyamok megrendezése, vizsgáztatás és bizonyítványok kiállítása az OAH előzetes engedélyéhez kötött. Főosztályunk a következő tanfolyamok szervezésére rendelkezik OAH engedéllyel:
- alap fokozatú sugárvédelmi ismereteket nyújtó kötelező tanfolyam (megfelelő létszám esetén tavasszal és ősszel, illetve felkérésre, igény szerint szervezzük)
- bővített fokozatú sugárvédelmi ismereteket nyújtó kötelező és továbbképző tanfolyam (évente kétszer, tavasszal és ősszel, illetve felkérésre szervezzük)
- átfogó fokozatú sugárvédelmi ismereteket nyújtó kötelező és továbbképző tanfolyam (évente szervezzük ősszel, továbbképzést megfelelő létszám esetén tavasszal is)
- sugárvédelmi szakértői képzés (évente egyszer ősszel szervezzük)
A Sugárorvostani Osztály a tanfolyamok adminisztatív és tematikus szervezését végzi, valamint az osztály dolgozói rendszeresen részt vesznek az oktatásban is.
Az atomenergiáról szóló 1996. évi CXVI. törvény egyes rendelkezéseinek végrehajtásáról szóló 16/2000. (VI. 8.) EüM rendeletben megfogalmazottak szerint a Sugárorvostani Osztály rendszeres sugárorvostani továbbképzést, és egyéni konzultációkat tart a „Sugársérültek ellátása” témában a kijelölt egészségügyi intézmények munkatársai részére, amely képzés a sugársérültek orvosi ellátására kijelölt egészségügyi intézmények szakmai felkészítésében része.
A fentieken kívül az Osztály dolgozói az alábbi graduális és posztgraduális képzéskben vezsnek részt előadókként vagy szervezőkként:
- Budapesti Műszaki Egyetem által szervezett sugárbiológiai tanfolyam orvosi sugárfizikus MSc hallgatóknak
- Sugárbiológiai kurzusok a Pécsi Tudományegyetem Általános Orvostudományi Karán
- Génterápiás kurzusok a Pécsi Tudományegyetem Általános Orvostudományi Karán
- Sugárterápiás szakorvos jelöltek sugárbiológiai elméleti és gyakorlati képzése
- Semmelweis Egyetem Egészségtudományi Kar Környezetegészségügyi Tanszékén „Sugáregészségügy” tantárgy oktatása





